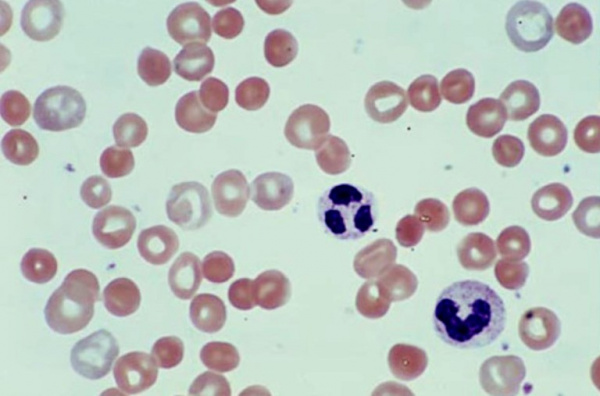
Аутоиммунная гемолитическая анемия

Врожденные дизэритропоэтические анемии - классификация, диагностика, лечение
Добавил пользователь Skiper Обновлено: 18.12.2025
Диагностика мегалобластической анемии - анализы
В большинстве случаев обследование больных начинается на фазе уже развитой мегалобластической анемии. Схематично оно развертывается в следующей последовательности: выявление анемии, определение ее мегалобластического характера, диагностирование дефицита витамина В12 или фолиевой кислоты (или исключение такой возможности), уточнение патофизиологического механизма недостаточности, установление нозологической единицы, в которой развился дефицит (возможно и условий, способствующих его развитию).
Отмеченная последовательность находится в обратном порядке по сравнению с последовательностью нарушений во времени; при этом, в создании дефицита названных двух витаминов различаются следующие три фазы: биохимическая (когда количество витаминов сокращается в среде организма), гематологическая (при которой возникает мегалобластоз) и клиническая (с уже определившейся анемией).
В ряде случаев причиной, вызывающей диагностическое исследование, является не анемия, а иные проявления (например, невропатия, расстройства пищеварения, мегалобластические изменения без анемии и пр.) или патологические состояния, потенциально могущие обусловить развитие соответствующих дефицитов (беременность, гемолитическая анемия, алкоголизм и пр.). Такое мероприятие проводится именно в целях своевременного выявления анемии. Вот почему приведенная выше схема исследований может измениться коренным образом.
В нижеследующем приводятся некоторые правила, которыми следует руководствоваться на различных этапах диагностического процесса.
Диагностирование мегалобластоза в принципе не сложное дело, когда заболевание предоставляется в уже полностью развитой форме. При этом учитываются костномозговые и периферические морфологические изменения с наличием признаков неэффективности эритропоэза (ранее описанных). Для постановки раннего диагноза представляют значение «незначительные» мегалобластические изменения (Hansen), которые заключаются в наличии промежуточных мегалобластов, гигантских гранулоцитов (более 5%, а возможно и 20% всех костномозговых клеток) и гиперсегментированных гранулоцитов в крови (подозрительное число 3 и 4-дольчатых клеток).
В отношении промежуточных мегалобластов необходимо учитывать артефакты, связанные с приготовлением мазка (даже и отдельные частные особенности). Гигантские миелоидные клетки развиваются при беременности, железодефицитной анемии, отдельных инфекционно-токсических состояниях и хронических заболеваниях почек, в то время как гиперсегментирование наблюдается также в качестве врожденного дефекта.

При полностью сложившегося мегалобластоза основными задачами дифференциальной диагностики являются отождествление «резкой задержки деления » (в связи с истощением запаса фолиевокислых солей или их метаболическим блокированием) при различных хронических гемолитических анемиях, также мегалобластоза — в случаях неподдающейся лечению анемии и эритремического миелоза (синдром di Guglielmo), когда, помимо обычно положительной реакции ШИК существует, в принципе, явное преобладание мегалобластических а диспластических сдвигов.
Диагностирование этиопатогенетической категории состоит, по существу, в отождествлении дефицита витамина В12 или фолиевой кислоты, критерии которого уже рассматривались. Определение витаминемии составляет наиболее точный способ, делающий возможным выявление дефицита даже на скрытой стадии; в клинике применяются также метаболические тесты.
Определение витамина В12 (в принципе в сыворотке) выявляет его понижение до менее 150 пг/мл («предел тревоги») или 100 пг/мл (явный дефицит), а иногда (при болезни Бирмера) до 20 пг/мл. «Искусственное» повышение его показателя наблюдается после инъецирования В12 при заболеваниях печени, особенно при хроническом гемобластном лейкозе. вот почему некоторые авторы отдают предпочтение определению этого витамина в эри троцитах (норма 100—300 нг/мл) (Kelly и Herbert).
Определение фолиевокислых солей в сыворотке указывает на раннее сокращение при фолиевом дефиците (до менее 3 нг/мл), равно как и при инфекциях, новообразованиях, железодефицитной анемии и пр.; неспецифический рост отмечается нередко при дефиците В12. С учетом этого предпочтительно проводить определение в цельной крови (при дефиците до 50 нг/мл; мегалобластоз появляеткх при менее 20—15 нг/мл).
Выделение с мочой метилмалоновой кислоты при дефиците В12 увеличивается до нескольких десятков мг/сутки (иногда резко, в частности в формах с невропатией), также при нарушении метаболизма пропионовой кислоты. Положительная реакция FIGlu отмечается не только у больных с фолиевым дефицитом, но также у страдающих болезнью Бирмера, заболеваниями печени, часто у беременных и пр. В процессе диагностирования использование терапевтического теста с введением физиологических доз витамина В12 (парентерально 1—5 мкг/сутки) или фолиевой кислоты (перорально 50—100 мкг/сутки) и дальнейшим наблюдением реакции ретикулоцитов — лишь в редких случаях оказывается необходимым.
В таком случае предполагается наличие выраженной анемии, что требует питания без соответствующих витаминов. Инфекции и прочие факторы могут обусловить неправильные результаты теста.
Патофизиологическое и этиологическое диагностирование проводится по данным анамнеза, клинического обследования и требуемых при этом лабораторных исследований. Так, при дифференцальной диагностике дефицита отмеченных двух витаминов анамнез, в котором значатся хроническая неполноценность питания (нередко в сочетании с алкоголизмом), повторная беременность, заболевания кишечника с преобладающим поражением тощей кишки, как и вообще желудочнокишечные расстройства с неполноценным поглощением подсказывают, в первую очередь, наличие фолиевого дефицита, в то время как иссчение желудка или подвздошной кишки и признаки нервного расстройства — говорят о наличии дефицита витамина В12.
Клиническое обследование часто усматривает в дефиците В12 признак поражения задних и боковых канатиков, в то время как симптоматология возможной невропатии алкоголиков у больного с фолиевой недостаточностью — иная. Среди лабораторных данных выявление желудочной ахилии составляет весьма важный признак, указывающий на наличие болезни Бирмера, однако, в отдельных случаях для уточнения дополнительно проводится реакция Шиллинга (например, у леченных больных).
В целях уточнения патофизиологического механизма и этиологии основного заболевания, его осложнений и сопутствующих болезней, в зависимости от случая, можно также прибегнуть к использовании ряда простых или специальных тестов, относящихся к различным медицинским специальностям.
Редактор: Искандер Милевски. Дата обновления публикации: 18.3.2021
Апластическая анемия ( Гипопластическая анемия )
Апластическая анемия – угнетение функции кроветворения красного костного мозга (эритроцитопоэза, лейкопоэза и тромбоцитопоэза), приводящее к пангемоцитопении. К основным клиническим проявлениям гематологического синдрома принадлежат головокружение, слабость, обмороки, одышка, покалывание в груди, кожные геморрагии, кровотечения, склонность к развитию инфекционно-воспалительных и гнойных процессов. Заболевание диагностируется на основании характерных изменений гемограммы, миелограммы и гистологического исследования трепанобиоптата. Лечение патологии включает проведение гемотрансфузий, иммуносупрессивной терапии, миелотрансплантации.
МКБ-10



Общие сведения
Апластическая (гипопластическая) анемия – тяжелое расстройство гемопоэза (чаще всех его звеньев), сопровождающееся развитием анемического, геморрагического синдромов и инфекционных осложнений. Развивается в среднем у 2 человек на 1 млн. населения в год. Приблизительно с одинаковой частотой патология поражает мужчин и женщин. Возрастные пики заболеваемости приходятся на возраст 10–25 и старше 50 лет. При данной патологии в костном мозге чаще нарушается образование всех трех типов клеточных элементов крови (эритроцитов, лейкоцитов и тромбоцитов), иногда - только одних эритроцитов; в зависимости от этого различают истинную и парциальную апластическую анемию. В гематологии данный вид анемии относится к числу потенциально фатальных заболеваний, приводящих к гибели 2/3 заболевших.

Причины
По происхождению апластическая анемия может быть врожденной (связанной с хромосомными аберрациями) и приобретенной (развившейся в течение жизни). Принято считать, что угнетение миелопоэза связано с появлением в красном костном мозге и крови цитотоксических T-лимфоцитов, производящих фактор некроза опухолей и γ-интерферон, которые в свою очередь подавляют ростки кроветворения. Запускать этот механизм могут различные внешнесредовые (химические соединения, физические явления, лекарственные вещества), а также эндогенные факторы (вирусы, аутоиммунные реакции). К числу наиболее значимых причин относят:
- Прием миелотоксических препаратов. Достоверно установлена связь анемии с приемом некоторых противоопухолевых, противосудорожных, антибактериальных, антитиреоидных, противомалярийных препаратов, транквилизаторов, препаратов золота и др., обладающих потенциальным миелотоксическим эффектом. Лекарственные вещества могут вызывать как прямое повреждение стволовых кроветворных клеток, так и опосредованное - через аутоиммунные реакции. Анемии, связанные с таким механизмом развития, называются лекарственными.
- Контакт с химическими и физическими агентами. Супрессию костного мозга может вызывать взаимодействие с органическими растворителями, соединениями мышьяка, бензольными соединениями, пестицидами, облучение всего тела. В некоторых случаях недостаточность гемопоэза является временной и обратимой - главными факторами здесь являются концентрация/доза вещества и время контакта. супрессию костного мозга.
- Вирусные инфекции. Из вирусных агентов наибольшее значение уделяется возбудителям гепатитов В, С и D. В этом случае гипопластическая анемия обычно развивается в течение полугода после перенесенного вирусного гепатита. При изучении патогенеза было замечено, что репликация вируса происходит в мононуклеарах крови и костного мозга, а также в иммунных клетках. Предполагается, что подавление миелопоэза в этом случае является своеобразным иммунным ответом, возникающим против клеток, несущих на своей поверхности вирусные антигены. Такой вид анемии выделяется в отдельную форму – постгепатитную. Среди других вирусных инфекций называются ЦМВ, инфекционный мононуклеоз, грипп.
Также описаны случаи панцитопении, вызванные инфицированием туберкулезом, интоксикацией, лучевой болезнью, лимфопролиферативными заболеваниями (тимомой, лимфомой, хроническим лимфобластным лейкозом), беременностью. Почти в половине наблюдений причину анемии выявить не удается - такие случаи относят к идиопатической форме.
Патогенез
В основе апластической анемии может лежать либо первичное повреждение гемопоэтических стволовых клеток, либо нарушение их эффективной дифференцировки. При наследственных анемиях недостаточность гемопоэза опосредована кариотипическими аберрациями, приводящими к нарушению репарации ДНК и невозможности репликации стволовых клеток костного мозга. В случае приобретенной анемии под влиянием этиофакторов наблюдается активация Т-клеток, которые начинают продуцировать цитокины (интерферон-гамма, ФНО), поражающие клетки-предшественники гемопоэза. В стволовых клетках костного мозга повышается экспрессия генов, отвечающих за апоптоз и активизацию клеточной гибели. Основные клинические проявления обусловлены пангемоцитопенией – снижением в составе крови всех ее форменных элементов (эритроцитов, лейкоцитов, тромбоцитов).
Классификация
Кроме различных этиологических вариантов (лекарственного, постгепатитного, идиопатического), различают острую (до 1 мес. течения), подострую (от 1 до 6 мес.) и хроническую (более 6 мес.) форму заболевания. Анемию, протекающую с избирательным угнетением эритропоэза, называют парциальной красноклеточной аплазией. На основании выраженности тромбо- и гранулоцитопении данная форма анемии подразделяется на 3 степени тяжести:
- очень тяжелую (тромбоцитов менее 20,0х109/л; гранулоцитов менее 0,2х109/л)
- тяжелую (тромбоцитов менее 20,0х109/л; гранулоцитов менее 0,5х109/л), по данным трепанобиопсии – низкая клеточность костного мозга (менее 30% от нормы)
- умеренную (тромбоцитов более 20,0х109/л; гранулоцитов более 0,5х109/л)
Симптомы апластической анемии
Поражение трех гемопоэтических ростков (эритро-, тромбоцито- и лейкопоэза) обусловливает развитие анемического и геморрагического синдромов, инфекционных осложнений. Дебют апластической анемии обычно происходит остро. Анемический синдром сопровождается общей слабостью и утомляемостью, бледностью кожи и видимых слизистых, шумом в ушах, головокружением, покалыванием в груди, одышкой при нагрузке.
Основным проявлением тромбоцитопении выступает геморрагический синдром. Больные отмечают появление петехий и экхимозов на коже, повышенную кровоточивость десен, спонтанные носовые кровотечения, меноррагии. Возможно возникновение гематурии, маточных и желудочно-кишечных кровотечений. Следствием лейкопении и агранулоцитоза служит частое развитие инфекционных процессов – стоматитов, пневмоний, инфекций кожи и мочевыводящих путей. Для апластической анемий нехарактерны похудание, лимфаденопатия, гепато- и спленомегалия – при этих признаках следует искать другую причину пангемоцитопении.
Врожденная апластическая анемия (синдром Фанкони) обычно развивается у детей в возрасте до 10 лет и кроме аплазии костного мозга характеризуется другими нарушениями: микроцефалией, гипоплазией почек, низкорослостью, аномалиями развития верхних конечностей (гипоплазией первой пястной и лучевой кости), гипоспадией, гиперпигментацией кожи, крайней степенью тугоухости и др. При наследственной анемии Эстрена-Дамешека отмечается тотальное поражение кроветворения и панцитопения при отсутствии врожденных аномалий развития. Для анемии Даймонда-Блекфена или парциальной красноклеточной аплазии характерно только снижение количества эритроцитов.

Осложнения
Летальный исход может быть обусловлен кровоизлияниями во внутренние органы, массивными кровотечениями, инфекционными осложнениями, анемической комой. Наиболее грозное из геморрагических осложнений – кровоизлияние в головной мозг (геморрагический инсульт). Больные склонны к частым и тяжело протекающим вирусным и бактериальным инфекциям респираторного тракта. Значительное или стремительное снижение уровня красных кровяных телец может привести к анемической коме. При молниеносной форме крайне быстро развиваются тяжелейшая анемия, иммунодефицит, коагулопатии, имеющие фатальные последствия.
Диагностика
Оценка гематологического статуса включает внимательный клинический осмотр и проведение тщательной лабораторной диагностики. При физикальном обследовании выявляется выраженная бледность или желтушность кожи, артериальная гипотония, тахикардия. Основу диагностического алгоритма составляет проведение общего и биохимического анализа крови, стернальной пункции, трепанобиопсии:
- Исследования крови. Для гемограммы при гипопластической анемии типичны эритро-, лейкоцито- и тромбоцитопения, нейтропения и относительный лимфоцитоз. Оценка биохимических показателей (печеночных проб, нефрологического комплекса, сывороточного железа, билирубина) информативна для исключения других анемий.
- Исследованиепунктата костного мозга. В миелограмме обнаруживается уменьшение количества миелокариоцитов и мегакариоцитов, снижение клеточности. В трепанобиоптате определяется замещение красного костного мозга жировым (желтым).
В рамках диагностического поиска апластическую анемию необходимо дифференцировать с мегабластными (В12-дефицитными, фолиеводефицитными) анемиями, идиопатической тромбоцитопенической пурпурой, пароксизмальной ночной гемоглобинурией, острым лейкозом.

Лечение апластической анемии
Больные с апластической анемией госпитализируются в специализированные отделения. Им обеспечиваются полная изоляция и асептические условия для предупреждения возможных инфекционных осложнений. Проведение эффективного лечения является сложной проблемой практической гематологии. В зависимости от уровня цитопении используются следующие лечебные подходы:
- Иммуносупрессиная терапия. При умеренной цитопении назначается фармакотерапия, включающая комбинацию антитимоцитарного иммуноглобулина и циклоспорина А. Поддерживающая терапия проводится анаболическими стероидами или их сочетанием с циклоспоринами.
- Гемотрансфузии. В комплексе с курсом иммуносупрессивной терапии при низких показателях красной крови показано проведение заместительной гемотрансфузионной терапии (переливание тромбоцитов и эритроцитарной массы), плазмафереза. Данная мера не оказывает воздействия на патогенетическое звено заболевания, но позволяет восполнить дефицит кровяных телец, не вырабатываемых костным мозгом.
- Трансплантация КМ и СК. Наиболее благоприятные прогнозы на долгосрочную выживаемость оказывает выполнение аллогенной трансплантации костного мозга. Однако ввиду сложности подбора иммунологически совместимого донора процедура используется ограниченно. В качестве экспериментальных подходов рассматриваются аутологичные трансплантации, пересадка стволовых клеток периферической крови. Больным с нетяжелой формой анемии может быть показано проведение спленэктомии, эндоваскулярной окклюзии селезеночной артерии.
Прогноз и профилактика
Прогноз определяется этиологической формой, тяжестью и остротой течения анемии. Критериями неблагоприятного исхода служат быстрое прогрессирование заболевания, тяжелый геморрагический синдром и инфекционные осложнения. После трансплантации костного мозга ремиссии удается достичь у 75–90% пациентов. Первичная профилактика данной разновидности анемии предполагает исключение влияния неблагоприятных внешнесредовых факторов, необоснованного применения лекарственных препаратов, предупреждение инфекционной заболеваемости и др. Пациентам с уже развившимся заболеванием требуется диспансерное наблюдение гематолога, систематическое обследование и длительная поддерживающая терапия.
2. Комплексная программа диагностики апластической анемии с определением прогностически значимых патогенетических особенностей заболевания. Методические рекомендации. - 2015.
4. Апластическая анемия: современные представления о патогенезе и терапии/ Айсариева Б. К., Раймжанов А. Р., Айтбаев К.// Молодой ученый. - 2011 - №9.
Дизэритропоэтическая анемия
Дизэритропоэтическая анемия — общее название группы патологий, в основе которых лежат нарушения костномозгового кроветворения (гемопоэза). Она встречается при поражении красного костного мозга, экзогенных воздействиях, дефиците нутриентов (цианокобаламина, фолиевой кислоты, железы). Основные симптомы: бледность кожи, частые головокружения, повышенная утомляемость и одышка при физической нагрузке. Диагностика анемии включает клинические и биохимические исследования крови, изучение костномозговых пунктатов, обследование органов ЖКТ. Лечение подбирается дифференцировано в соответствии с этиологическими факторами заболевания.

Анемиями разной степени выраженности страдает 24,8% населения планеты. Среди беременных женщин они встречаются у 41,8%, среди небеременных —у 30,2%. У мужчин состояние развивается намного реже — в 12,7% случаев. Распространенность проблемы среди пожилого населения достигает 23,9%. Дизэритропоэтические нарушения составляют до 88% от всех видов анемий, имеют тяжелые осложнения и не всегда поддаются лечению, что подчеркивает актуальность патологии в практике гематолога.

Поскольку дизэритропоэтические анемии составляют большинство нарушений красного ростка гемопоэза, их этиологическая структура отличается большим разнообразием. Особую группу занимают наследственные заболевания, вызванные генными мутациями: гемоглобинопатии, талассемии, анемия Фанкони. Остальные причины подразделяются на следующие категории:
- Экзогенные влияния. Образования эритроцитов в костном мозге ухудшается под действием физических (радиация), химических (яды, лекарства — цитостатики, некоторые антибиотики), биологических факторов (вирусы гепатитов, Эпштейн-Барр).
- Дефицит нутриентов. Чаще болезнь возникает вследствие недостатка железа из-за алиментарных нарушений, чрезмерного расходования этого микроэлемента (при хронических кровотечениях, беременности, воспалительных реакциях). Реже симптомы вызваны нехваткой витамина В12, фолиевой кислоты.
- Онкопатология. Опухоли системы крови (лейкозы) и метастазы в костный мозг замещают нормальные ростки гемопоэза, снижают образование эритроцитов. Также при онкологических процессах ухудшается усвоение полезных веществ в кишечнике, чем обусловлена нутритивной недостаточностью.
Механизм развития болезни определяется этиологическими факторами. Экзогенные вредные воздействия нарушают синтез белков и нуклеиновых кислот в стволовых клетках, провоцируя их гипоплазию, а также изменяют параметры физико-химической среды костного мозга. В некоторых случаях патогенез дизэритропоэтических расстройств дополняется прямым разрушением клеток-предшественниц цитотоксическими лимфоцитами, специфическими антителами.
При дефицитных состояниях отмечаются нарушения на разных этапах образования эритроцита, насыщения его структурно полноценным гемоглобином. При низком содержании В12 либо фолиевой кислоты патология формируется на стадии синтеза ДНК и деления красных кровяных телец. Нехватка железа снижает образование гема, нарушает его соединение с глобином. Железодефицит также уменьшает число ферментов в эритроцитах, снижает устойчивость клеток к гемолизу.
- Апластические процессы. Развиваются при повреждении стволовых костномозговых клеток. В отдельную разновидность выделяют метапластические состояния, при которых красный росток кроветворения вытесняется опухолевыми клетками.
- Дефицитные состояния. Связаны с дефицитом химических веществ, необходимых для формирования эритроцитов. К ним относят мегалобластные (В12-дефицитные, фолиеводефицитные), железодефицитные, порфиринодефицитные (железорефрактерные).
- Талассемии. Формируются при генетически обусловленных нарушениях структуры белковых соединений гемоглобина. На основе данных о локализации генной мутации бывают альфа-, бета- и дельта-талассемии.
- Гемоглобинопатии. Проявляются при наследственном изменении структуры молекулы гемоглобина, синтезе дефектных белков. Самый известный представитель этой группы — серповидно-клеточная анемия.
Симптомы дизэритропоэтических анемий
Клиническая картина состоит из общих признаков недостатка гемоглобина и патогномоничных проявлений, вызванных первопричиной болезни. К основным симптомам относят слабость, быструю утомляемость, снижение работоспособности — признаки хронической гипоксии. Также пациенты жалуются на одышку, непереносимость физических нагрузок.
Типичные признаки анемической гипоксии включают частые приступы головокружения, шум в ушах, общее недомогание. Зачастую у больных снижается аппетит, наблюдаются расстройства полового влечения. Важным симптомом считается патологическая бледность кожных покровов, видимых слизистых, ногтевых лож. Длительно протекающая анемия приводит к разрушению ногтевых пластин по типу койлонихии.
Патогномоничные симптомы дефицитных дизэритропоэтических анемий: при нехватке В12 — «малиновый язык», нарушение чувствительности конечностей, при нехватке железа — трещины в углах рта, выпадение волос, извращение вкусовых пристрастий. Анемические состояния у страдающих онкопатологией сопровождаются потерей веса, увеличением лимфатических узлов, частыми инфекционными заболеваниями.
При апластическом варианте нарушаются все ростки кроветворения, поэтому в крови снижается уровень лейкоцитов, тромбоцитов. Классические признаки болезни дополняются частыми инфекциями на фоне снижения иммунитета, спонтанными кровотечениями, беспричинным появлением кровоподтеков на коже. При всех видах дизэритропоэтических анемий бывают кардиопатологии, которые проявляются миокардиодистрофией, сердечной недостаточностью.
Тяжелое течение чревато развитием анемической прекомы, для которой типична сильная сонливость, тахикардия, расстройства сознания. Если человеку вовремя не оказать помощь, состояние переходит в кому: пациент теряет сознание, у него снижаются рефлексы, нарушается дыхание и кровообращение. Особо опасна пернициозная кома, характеризующаяся резкой гипотермией, арефлексией, критической ишемией головного мозга.
При физикальном осмотре гематолог находит внешние симптомы анемии, изучает состояние придатков кожи, оценивает основные показатели работы сердца. Патогномоничные признаки, такие как «малиновый язык», сидеропенический синдром и т. д., наталкивают врача на причины нарушений гемопоэза. Для подтверждения диагноза и выяснения этиологических факторов назначают полный комплекс обследований, в который входят:
- Гемограмма. В результатах анализа крови специалист обращает внимание на падения числа эритроцитов ниже возрастной нормы, уменьшение показателя гемоглобина. Врач уточняет вид дизэритропоэтических анемий по цветовому показателю, наличию патологических форм клеток (мегалобластов, микроцитов, пойкилоцитов), уровню ретикулоцитов.
- Биохимические тесты. Железодефицитные состояния диагностируют по снижению уровней ферритина и трансферрина, повышению железосвязывающей способности сыворотки (ОЖСС). Для верификации других дизэритропоэтических анемий используют анализ крови на В12, фолиевую кислоту. Чтобы исключить гемолитический характер патологии, определяют уровень общего и непрямого билирубина.
- Пункция костного мозга. Исследование костномозговой ткани показывает угнетение ростков кроветворения (при апластической анемии), замещение их мутантными злокачественными клетками (при лейкозе), снижение числа сидеробластов (при недостатке в организме железа).
- Обследование ЖКТ. ЭФГДС и колоноскопия показаны больным с соответствующими жалобами для исключения хронических кровопотерь, выявления симптомов атрофического гастрита. Для уточнения диагноза эндоскопию дополняют рентгенографией с контрастированием, УЗИ органов брюшной полости, анализом кала на скрытую кровь.
Лечение дизэритропоэтических анемий
Консервативная терапия
Лечение проводится в 2-х направлениях: улучшение гематологических показателей и устранение первопричины заболевания. При нутриентных дефицитах необходима коррекция питания с насыщением рациона недостающими витаминами и микроэлементами. Диетотерапия дополняется пероральным или парентеральным введением железа, В12 или фолиевой кислоты, чтобы быстро восстановить гемопоэз.
Особую сложность представляет лечение апластических форм анемии. Учитывая причины болезни, пациентам назначают иммуносупрессивные препараты, анаболические стероиды, моноклональные антитела. При тяжелом течении любого вида дизэритропоэтической анемии в качестве экстренной помощи используют гемотрансфузионную терапию: переливание эритроцитарной массы, тромбоцитарной массы, гранулоцитарного концентрата.
Хирургическое лечение
Трансплантация гемопоэтических стволовых клеток — наиболее перспективное направление коррекции апластических, наследственных дизэритропоэтических анемий. Процедура повышает шансы на долгосрочную выживаемость, улучшает качество жизни больных. При врожденных нарушения кроветворения, сопровождающихся увеличением селезенки, показана спленэктомия.
Большинство дефицитных анемий успешно корректируются, тогда как при апластических дизэритропоэтических и генетически обусловленных заболеваниях прогноз сомнительный. Продолжительность жизни больного зависит от тяжести патологии, полноты применяемых терапевтических методов. Профилактика предполагает рациональное витаминизированное питание, назначение биодобавок людям из групп риска, предупреждение экзогенных воздействий на костный мозг.
1. Дизэритропоэтические анемии. Классификация. Этиология и патогенез железодефицитной анемии/ Н.П. Чеснокова, Т.А. Неважай, М.Н. Бизенкова, В.В. Моррисон// Международный журнал прикладных и фундаментальных исследований. — 2015.
2. Дизэритропоэтические анемии. Этиология и патогенез в12-дефицитной анемии, гематологическая характеристика/ Н.П. Чеснокова, Т.А. Неважай, М.Н. Бизенкова, В.В. Моррисон// Международный журнал прикладных и фундаментальных исследований. — 2015.
3. Анемии: виды, клинические проявления, лечение/ Е.Ф. Шевченко, П.Ю. Доронина// Научно-практический электронный журнал «Аллея Науки». — 2020.
Врожденные дизэритропоэтические анемии - классификация, диагностика, лечение
Врожденные дисэритропоэтические анемии (ВДА) составляют особую группу наследственных анемий, характеризующихся неэффективностью эритропоэза, специфической морфологией костномозговых эритробластов, вторичным гемохроматозом и устойчивостью к лечению.
По изменениям эритробластов, установленным с помощью оптического микроскопа и условиям, ведущим к расплавлению эритроцитов в пробирке, Heimpel и Wendt выделили следующие три вида хронической дисэритропоэтической анемии: mun I — характеризующийся наличием мегалобластоидных эритробластов с межядерными хроматинными мостиками; тип II — характеризующийся наличием многоядерных эритробластов и положительной реакцией расплавления с подкисленной сывороткой (Ham); III тип — характеризующийся наличием многоядерных эритробластов.
В 1969 г. Crookston предложил следующее название для II типа врожденной дизэритропоэтической анемии: "hereditary erythroblastic multinuclearity with a positive acidified serum test (HEMPAS)". Недавно была описана разновидность ВДА типа II, при которой реакция Ham дала отрицательный результат (Weatherall D.J. и сотр., Hurby М.А. и сотр., McBride J.A. и сотр.), равно как и вариант специфического серологического поведения но без характерных морфологических аномалий (Van Dorpe A.).
У отдельных эритробластов хроматинная структура стертая, со слабо окрашенными однородными поверхностями а ядро не отграничено четко от окружающей его цитоплазмы. К другим характерным морфологическим изменениям относятся: сегментирование ядра с неполным делением; двухядрышковые клетки с ядрами разных величины, строения и окрашиваемости; пары эритробластов, связанные между собой мостиками хроматина разной длины. В макрофагах костного мозга показатель гемосидерина завышен. Число сидеробластов умеренно большое. Под электронным микроскопом выявляются расширение пор клеточной оболочки, уплотнение, вакуолизация и распад ядерного хроматина.
В отдельных случаях при врожденной дисэритропоэтической анемии типа I испытание на расплавление с применением сыворотки анти-i дает положительный результат.

Мазок крови при врожденной дизэритропоэтической анемии
10—35% полихроматофильных и оксифильных эритробластов — двух- или многоядрышковые, притом отмечается наличие значительного числа кариорексисов. У некоторых больных обнаруживаются макрофаги, пожирающие эритробластов и клетки „Gaucher-like" или гистиоцитов с синей зернистостью. В макрофагах костного мозга показатель гемосидерина завышен, в то время как в увеличенном проценте сидеробластов обнаруживаются крупные многочисленные зерна железа. Двух- или многоядерные эритробласты дают шикотрицательную реакцию. Под электронным микроскопом у 90% эритробластов наблюдаются оболочковые структуры (цистерны), расположенные параллельно клеточной оболочке. Подобное строение отмечается также у малого процента (1%) эритроцитов крови.
Ауторентгенографическое исследование костномозговых клеток с помощью тимидина Н3 выявляет тот факт, что двух- и многоядрышковые клетки остаются немаркированными. При врожденной дисэритропоэтической анемии типа II эритроциты напоминают о таковых при ночной пароксизмальной гемоглобинурии, поскольку они расплавляются под влиянием некоторых нормально подкисленных сывороток. Однако кислое расплавление крови не выявляется в сыворотке больного. Под воздействием сывороток анти-i и анти-I эритроциты врожденной дисэритропоэтической анемии типа II подвергаются процессам агглютинации и расплавления. Испытание с водой и сахаром дает отрицательный результат.
Серологическая аномалия связана с пороком оболочки эритроцита. Объяснение положительного результата реакции Ham следует искать в наличии специфического антигена HEMPAS реагирующего с естественным ИгМ, который находится в 30% нормальных сывороток. В эритроцитах наблюдается высокая концентрация антигена I и сохранение антигена i плодного типа. Антигены, неправильно расположенные на поверхности эритроцитов при врожденной дисэритропоэтической анемии типа II — результат сокращения покровной неураминовой кислоты и недостатков в сокращающихся элементах оболочки (Lewis S.M., Verwilghen R.L.).
У страдающих врожденной дисэритропоэтической анемией типа II наблюдается выраженное повышение активности отдельных эритроцитных ферментов (глюкозо-фосфатизомераза, триозо-фосфатизомераза, глиоксалаз I, фосфорил-фосфорибозилтрансфераза). Ацетилхолинэстераза эритроцитов несколько занижена. У 2 больных, страдающих ВДА типа II, определенных в Бухарестской клинике гематологии показатель щелочной фосфатазы лейкоцитов (ЩФЛ) равнялся нулю. Это подсказывает мысль о том, что основное нарушение не ограничивается эритроидным рядом а видимо распространяется и на остальные костномозговые клеточные ряды (дефект полипотентной клетки-штамм?) (Колицэ и сотр.).
Диагностика врожденной дизэритропоэтической анемии. Виды врожденной дисэритропоэтической анемии нетрудно распознать по характерным аномалиям эритробластов костного мозга и отличительному серологическому поведению. Так, например, это заболевание типа II отличается от ночной пароксизмальной гемоглобинуриитем,что испытание на расплавление с помощью подкисленной сыворотки дает положительный результат лишь при использовании определенных сывороток, в то время как результаты испытаний с применением сукроза и подслащенной сахаром воды — отрицательны.
При ночной пароксизмальной гемоглобинурии костный мозг нормобластический, при этом показатели наличия в нем гемосидерина и сидеробластов занижены, в то время как ретикулоцитов — резко завышен. Значительное число двух- или многоядерных эритробластов отмечено при эритролейкемии. У страдающих врожденной дисэритроэпоэтической анемией эритробласты шикотрицательные, в отличие от эритролейкемии, при которой эта реакция дает шикположительный результат.
Терапия врожденной дизэритропоэтической анемии. Назначение железа протршопоказано. Переливание способствует усугублению гемохроматоза. В целях сокращения запасов железа были испробованы лечение препаратом десфериоксамин и вскрытием вены. В отдельных случаях спленэктомия способствовала росту показателя гемоглобина.
Гемолитическая анемия
Гемолитическая анемия – патология эритроцитов, отличительным признаком которой является ускоренное разрушение красных кровяных телец с высвобождением повышенного количества непрямого билирубина. Для данной группы заболеваний типично сочетание анемического синдрома, желтухи и увеличения размеров селезенки. В процессе диагностики исследуется общий анализ крови, уровень билирубина, анализ кала и мочи, УЗИ органов брюшной полости; проводится биопсия костного мозга, иммунологические исследования. В качестве методов лечения используется медикаментозная, гемотрансфузионная терапия; при гиперспленизме показана спленэктомия.


Гемолитическая анемия (ГА) - малокровие, обусловленное нарушением жизненного цикла эритроцитов, а именно преобладанием процессов их разрушения (эритроцитолиза) над образованием и созреванием (эритропоэзом). Данная группа анемий очень обширна. Их распространенность неодинакова в различных географических широтах и возрастных когортах; в среднем патология встречается у 1% населения. Среди прочих видов анемий на долю гемолитических приходится 11%. Патология характеризуется укорочением жизненного цикла эритроцитов и их распадом (гемолизом) раньше времени (через 14-21 день вместо 100-120 суток в норме). При этом разрушение эритроцитов может происходить непосредственно в сосудистом русле (внутрисосудистый гемолиз) или в селезенке, печени, костном мозге (внесосудистый гемолиз).
Этиопатогенетическую основу наследственных гемолитических синдромов составляют генетические дефекты мембран эритроцитов, их ферментных систем либо структуры гемоглобина. Данные предпосылки обусловливают морфофункциональную неполноценность эритроцитов и их повышенное разрушение. Гемолиз эритроцитов при приобретенных анемиях наступает под влиянием внутренних факторов или факторов окружающей среды, среди которых:
- Аутоиммунные процессы. Образование антител, агглютинирующих эритроциты, возможно при гемобластозах (остром лейкозе, хроническом лимфолейкозе, лимфогранулематозе), аутоиммунной патологии (СКВ, неспецифическом язвенном колите), инфекционных заболеваниях (инфекционном мононуклеозе, токсоплазмозе, сифилисе, вирусной пневмонии). Развитию иммунных гемолитических анемий могут способствовать посттрансфузионные реакции, профилактическая вакцинация, гемолитическая болезнь плода.
- Токсическое действие на эритроциты. В ряде случаев острому внутрисосудистому гемолизу предшествует отравление мышьяковистыми соединениями, тяжелыми металлами, уксусной кислотой, грибными ядами, алкоголем и др. Вызывать разрушение клеток крови может прием определенных лекарств (противомалярийных препаратов, сульфаниламидов, производных нитрофуранового ряда, анальгетиков).
- Механическое повреждение эритроцитов. Гемолиз эритроцитов может наблюдаться при тяжелых физических нагрузках (длительной ходьбе, беге, лыжном переходе), при ДВС-синдроме, малярии, злокачественной артериальной гипертензии, протезировании клапанов сердца и сосудов, проведении гипербарической оксигенации, сепсисе, обширных ожогах. В этих случаях под действием тех или иных факторов происходит травматизация и разрыв мембран изначально полноценных эритроцитов.

Центральным звеном патогенеза ГА является повышенное разрушение эритроцитов в органах ретикулоэндотелиальной системы (селезенке, печени, костном мозге, лимфатических узлах) или непосредственно в сосудистом русле. При аутоиммунном механизме анемии происходит образование антиэритроцитарных АТ (тепловых, холодовых), которые вызывают ферментативный лизис мембраны эритроцитов. Токсические вещества, являясь сильнейшими окислителями, разрушают эритроцит за счет развития метаболических, функциональных и морфологических изменений оболочки и стромы красных кровяных телец. Механические факторы оказывают прямое воздействие на клеточную мембрану. Под влиянием этих механизмов из эритроцитов выходят ионы калия и фосфора, а внутрь поступают ионы натрия. Клетка разбухает, при критическом увеличении ее объема наступает гемолиз. Распад эритроцитов сопровождаются развитием анемического и желтушного синдромов (так называемой «бледной желтухой»). Возможно интенсивное окрашивание кала и мочи, увеличение селезенки и печени.
В гематологии гемолитические анемии подразделяются на две большие группы: врожденные (наследственные) и приобретенные. Наследственные ГА включают следующие формы:
- эритроцитарные мембранопатии (микросфероцитоз – болезнь Минковского-Шоффара, овалоцитоз, акантоцитоз) – анемии, обусловлены структурными аномалиями мембран эритроцитов
- ферментопении (энзимопении) – анемии, вызванные дефицитом тех или иных ферментов (глюкозо-6-фосфатдегидрогеназы, пируваткиназы и др.)
- гемоглобинопатии- анемии, связанные с качественными нарушениями структуры гемоглобина или изменением соотношения его нормальных форм (талассемия, серповидно-клеточная анемия).
Приобретенные ГА подразделяются на:
- мембранопатии приобретенные (пароксизмальная ночная гемоглобинурия – б-нь Маркиафавы-Микели, шпороклеточная анемия)
- иммунные (ауто- и изоиммунные) – обусловлены воздействием антител
- токсические – анемии, обусловленные воздействием химических веществ, биологических ядов, бактериальных токсинов
- механические - анемии, вызванные механическим повреждением структуры эритроцитов (тромбоцитопеническая пурпура, маршевая гемоглобинурия)
Симптомы
Наследственные мембранопатии, ферментопении и гемоглобинопатии
Наиболее распространенной формой данной группы анемий является микросфероцитоз, или болезнь Минковского-Шоффара. Наследуется по аутосомно-доминантному типу; обычно прослеживается у нескольких представителей семьи. Дефектность эритроцитов обусловлена дефицитом в мембране актомиозиноподобного белка и липидов, что приводит к изменению формы и диаметра эритроцитов, их массивному и преждевременному гемолизу в селезенке. Манифестация микросфероцитарной ГА возможна в любом возрасте (в младенчестве, юношестве, старости), однако обычно проявления возникают у детей старшего возраста и подростков. Тяжесть заболевания варьирует от субклинического течения до тяжелых форм, характеризующихся часто повторяющимися гемолитическими кризами. В момент криза нарастает температура тела, головокружение, слабость; возникают боли в животе и рвота.
Основным признаком микросфероцитарной гемолитической анемии служит желтуха различной степени интенсивности. Вследствие высокого содержания стеркобилина кал становится интенсивно окрашенным в темно-коричневый цвет. У пациентов с болезнь Минковского-Шоффара наблюдается склонность к образованию камней в желчном пузыре, поэтому часто развиваются признаки обострения калькулезного холецистита, возникают приступы желчной колики, а при закупорке холедоха конкрементом - обтурационная желтуха. При микросфероцитозе во всех случаях увеличена селезенка, а у половины пациентов – еще и печень. Кроме наследственной микросфероцитарной анемии, у детей часто встречаются другие врожденные дисплазии: башенный череп, косоглазие, седловидная деформация носа, аномалии прикуса, готическое нёбо, полидактилия или брадидактилия и пр. Пациенты среднего и пожилого возраста страдают трофическими язвами голени, которые возникают в результате гемолиза эритроцитов в капиллярах конечностей и плохо поддаются лечению.
Энзимопенические анемии связаны с недостатком определенных ферментов эритроцитов (чаще - Г-6-ФД, глутатион-зависимых ферментов, пируваткиназы и др). Гемолитическая анемия может впервые заявлять о себе после перенесенного интеркуррентного заболевания или приема медикаментов (салицилатов, сульфаниламидов, нитрофуранов). Обычно заболевание имеет ровное течение; типична «бледная желтуха», умеренная гепатоспленомегалия, сердечные шумы. В тяжелых случаях развивается ярко выраженная картина гемолитического криза (слабость, рвота, одышка, сердцебиение, коллаптоидное состояние). В связи с внутрисосудистым гемолизом эритроцитов и выделением гемосидерина с мочой последняя приобретает темный (иногда черный) цвет. Особенностям клинического течения гемоглобинопатий - талассемии и серповидно-клеточной анемии посвящены самостоятельные обзоры.
Приобретенные гемолитические анемии
Среди различных приобретенных вариантов чаще других встречаются аутоиммунные анемии. Для них общим пусковым фактором выступает образование антител к антигенам собственных эритроцитов. Гемолиз эритроцитов может носить как внутрисосудистый, так и внутриклеточный характер. Гемолитический криз при аутоиммунной анемии развивается остро и внезапно. Он протекает с лихорадкой, резкой слабостью, головокружением, сердцебиением, одышкой, болями в эпигастрии и пояснице. Иногда острым проявлениям предшествуют предвестники в виде субфебрилитета и артралгий. В период криза стремительно нарастает желтуха, не сопровождающаяся кожным зудом, увеличивается печень и селезенка. При некоторых формах аутоиммунных анемий больные плохо переносят холод; в условиях низких температур у них может развиваться синдром Рейно, крапивница, гемоглобинурия. Вследствие недостаточности кровообращения в мелких сосудах возможны осложнения в виде гангрены пальцев ног и рук.
Токсические анемии протекают с прогрессирующей слабостью, болями в правом подреберье и поясничной области, рвотой, гемоглобинурией, высокой температурой тела. Со 2-3 суток присоединяется желтуха и билирубинемия; на 3-5 сутки возникает печеночная и почечная недостаточность, признаками которых служат гепатомегалия, ферментемия, азотемия, анурия. Отдельные виды приобретенных гемолитических анемий рассмотрены в соответствующих статьях: «Гемоглобинурия» и «Тромбоцитопеническая пурпура», «Гемолитическая болезнь плода».
Каждый вид ГА имеет свои специфические осложнения: например, ЖКБ – при микросфероцитозе, печеночная недостаточность – при токсических формах и т.д. К числу общих осложнений относятся гемолитические кризы, которые могут провоцироваться инфекциями, стрессами, родами у женщин. При остром массивном гемолизе возможно развитие гемолитической комы, характеризующейся коллапсом, спутанным сознанием, олигурией, усилением желтухи. Угрозу жизни больного несут ДВС-синдром, инфаркт селезенки или спонтанный разрыв органа. Неотложной медицинской помощи требуют острая сердечно-сосудистая и почечная недостаточность.
Определение формы ГА на основе анализа причин, симптоматики и объективных данных относится к компетенции гематолога. При первичной беседе выясняется семейный анамнез, частота и тяжесть протекания гемолитических кризов. В процессе осмотра оценивается окраска кожных покровов, склер и видимых слизистых, производится пальпация живота для оценки величины печени и селезенки. Сплено- и гепатомегалия подтверждается при проведении УЗИ печени и селезенки. Лабораторный диагностический комплекс включает:
- Исследование крови. Изменения в гемограмме характеризуются нормо- или гипохромной анемией, лейкопенией, тромбоцитопенией, ретикулоцитозом, ускорением СОЭ. В биохимических пробах крови определяется гипербилирубинемия (увеличение фракции непрямого билирубина), увеличение активности лактатдегидрогеназы. При аутоиммунных анемиях большое диагностическое значение имеет положительная проба Кумбса.
- Анализы мочи и кала. Исследование мочи выявляет протеинурию, уробилинурию, гемосидеринурию, гемоглобинурию. В копрограмме повышено содержание стеркобилина.
- Миелограмму. Для цитологического подтверждения выполняется стернальная пункция. Исследование пунктата костного мозга обнаруживает гиперплазию эритроидного ростка.
В процессе дифференциальной диагностики исключаются гепатиты, цирроз печени, портальная гипертензия, гепатолиенальный синдром, порфирии, гемобластозы. Пациента консультируют гастроэнтеролог, клинический фармаколог, инфекционист и другие специалисты.
Лечение
Различные формы ГА имеют свои особенности и подходы к лечению. При всех вариантах приобретенной гемолитической анемии необходимо позаботиться об устранении влияния гемолизирующих факторов. Во время гемолитических кризов больным необходимы инфузии растворов, плазмы крови; витаминотерапия, по необходимости – гормоно- и антибиотикотерапия. При микросфероцитозе единственно эффективным методом, приводящим к 100 % прекращению гемолиза, является спленэктомия.
При аутоиммунной анемии показана терапия глюкокортикоидными гормонами (преднизолоном), сокращающая или прекращающая гемолиз. В некоторых случаях требуемый эффект достигается назначением иммунодепрессантов (азатиоприна, 6-меркаптопурина, хлорамбуцила), противомалярийных препаратов (хлорохина). При резистентных к медикаментозной терапии формах аутоиммунной анемии выполняется спленэктомия. Лечение гемоглобинурии предполагает переливание отмытых эритроцитов, плазмозаменителей, назначение антикоагулянтов и антиагрегантов. Развитие токсической гемолитической анемии диктует необходимость проведения интенсивной терапии: дезинтоксикации, форсированного диуреза, гемодиализа, по показаниям – введение антидотов.
Течение и исход зависят от вида анемии, тяжести протекания кризов, полноты патогенетической терапии. При многих приобретенных вариантах устранение причин и полноценное лечение приводит к полному выздоровлению. Излечения врожденных анемий добиться нельзя, однако возможно достижение длительной ремиссии. При развитии почечной недостаточности и других фатальных осложнений прогноз неблагоприятен. Предупредить развитие ГА позволяет профилактика острых инфекционных заболеваний, интоксикаций, отравлений. Запрещается бесконтрольное самостоятельное использование лекарственных препаратов. Необходимо тщательная подготовка пациентов к гемотрансфузиям, вакцинации с проведением всего комплекса необходимых обследований.
4. Клинические рекомендации по диагностике и лечению аутоиммунных гемолитический анемий/ Цветаева Н.В., Никулина О.Ф. - 2014.
Читайте также:
